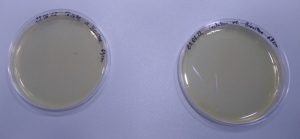

Die Aurora Lichtwerke haben sich auf Spezialanwendungen fokussiert. Ein Produkt im
Bereich Retrofit ist hier die LED Röhre T8 „Aurosun Care“.
Diese LED Röhre reduziert Schimmel und Bakterien
Mit den LED Röhren Aurosun Care kann eine energieeffiziente, qualitativ hochwertige
Allgemeinbeleuchtung realisiert werden. Parallel emittieren die Aurosun Care LED Röhren im
violettem Wellenlängenbereich ein zusätzliches erhöhtes und genau definiertes Lumen-Paket.
Eine Studie, die im Jahr 2017 veröffentlicht wurde, untersuchte die Wirkung von Licht im Bereich 405
bis 470 Nanometer auf Schimmel, der auf Oberflächen in Innenräumen wuchs. Die Forscher fanden
heraus, dass das Licht in diesem Bereich wirksam war, um das Wachstum von Schimmel zu hemmen
und zu neutralisieren. Eine andere Studie aus dem Jahr 2018 ergab ähnliche Ergebnisse und zeigte,
dass Licht im Bereich von 450 nm das Wachstum von Schimmelpilzen signifikant reduzieren konnte.
Einige Studien haben gezeigt, dass Licht im Bereich 405 bis 470 Nanometer Bakterien wie
Staphylococcus aureus, Escherichia coli und Pseudomonas aeruginosa sowie Schimmelpilze wie
Aspergillus fumigatus und Candida albicans abtöten kann. Eine Studie aus dem Jahr 2018 ergab, dass
die Exposition von Bakterienkulturen gegenüber Licht bei 405 nm über einen Zeitraum von 30
Minuten zu einer signifikanten Reduktion der Bakterienzahl führte.
Mit Aurosun Care beleuchteter Probenträger mit Abstrich einer Toilette und Tastatur nach 100 Std.

Ohne Aurosun Care beleuchteter Probenträger mit Abstrich einer Toilette und Tastatur nach 100 Std.
Licht im Bereich 405 bis 470 Nanometer wird aufgrund seiner antimikrobiellen Eigenschaften als
vielversprechende Technologie zur Abtötung von Bakterien, Viren und Schimmelpilzen betrachtet.
Diese Eigenschaften beruhen auf der Fähigkeit des Lichts, spezifische Moleküle in den Zellen von
Mikroorganismen zu aktivieren, was letztendlich zu deren Abtötung führen kann.
Die Wirkung des Lichts auf den Feinstaub beginnt damit, dass Photonen auf die Oberfläche der
Partikel treffen und die Bindungen zwischen den Molekülen aufbrechen. Dadurch entstehen reaktive
Teilchen wie Radikale und Ionen, die mit Sauerstoff und Stickstoff in der Luft reagieren. Dadurch
entstehen chemische Verbindungen wie Ozon, Hydroxylradikale und Peroxidradikale, die wiederum
die Feinstaubpartikel oxidieren können.
Die Oxidation des Feinstaubs bewirkt eine chemische Veränderung der Partikel, die sie größer und
schwerer macht. Dadurch können sie schneller aus der Luft entfernt werden und ihre schädliche
Wirkung auf die Gesundheit der Menschen und der Umwelt verringern.
Bei Messungen mit dem unabhängigen Institut Domatec konnte die Wirkung der
Aurosun Care LED Röhre T8 bestätigt und ein Wirkzertifikat ausgestellt werden.
Hier finden Sie das Zertifikat: Wirkzertifikat für Aurosun Care

